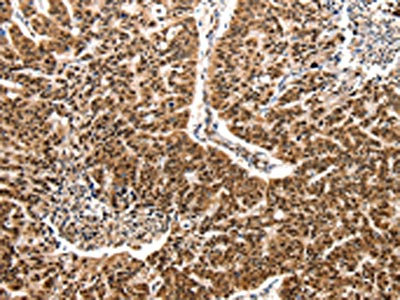

-
中文名稱:CCL2兔多克隆抗體
-
貨號:CSB-PA012674
-
規格:¥1100
-
圖片:
-
其他:
產品詳情
-
Uniprot No.:
-
基因名:
-
別名:C-C motif chemokine 2 antibody; CCL2 antibody; CCL2_HUMAN antibody; Chemokine (C C motif) ligand 2 antibody; GDCF 2 antibody; GDCF-2 antibody; GDCF2 antibody; HC11 antibody; HSMCR30 antibody; JE antibody; MCAF antibody; MCP 1 antibody; MCP-1 antibody; MCP1 antibody; MGC9434 antibody; Monocyte chemoattractant protein 1 antibody; Monocyte chemotactic and activating factor antibody; Monocyte chemotactic protein 1 antibody; Monocyte secretory protein JE antibody; SCYA2 antibody; Small inducible cytokine A2 (monocyte chemotactic protein 1; homologous to mouse Sig je) antibody; Small inducible cytokine A2 antibody; Small inducible cytokine subfamily A (Cys Cys); member 2 antibody; Small-inducible cytokine A2 antibody; SMC CF antibody; SMC-CF antibody; SMCCF antibody
-
宿主:Rabbit
-
反應種屬:Human
-
免疫原:Synthetic peptide of Human CCL2
-
免疫原種屬:Homo sapiens (Human)
-
標記方式:Non-conjugated
-
抗體亞型:IgG
-
純化方式:Antigen affinity purification
-
濃度:It differs from different batches. Please contact us to confirm it.
-
保存緩沖液:-20°C, pH7.4 PBS, 0.05% NaN3, 40% Glycerol
-
產品提供形式:Liquid
-
應用范圍:ELISA,IHC
-
推薦稀釋比:
Application Recommended Dilution ELISA 1:1000-1:10000 IHC 1:50-1:200 -
Protocols:
-
儲存條件:Upon receipt, store at -20°C or -80°C. Avoid repeated freeze.
-
貨期:Basically, we can dispatch the products out in 1-3 working days after receiving your orders. Delivery time maybe differs from different purchasing way or location, please kindly consult your local distributors for specific delivery time.
-
用途:For Research Use Only. Not for use in diagnostic or therapeutic procedures.
相關產品
靶點詳情
-
功能:Acts as a ligand for C-C chemokine receptor CCR2. Signals through binding and activation of CCR2 and induces a strong chemotactic response and mobilization of intracellular calcium ions. Exhibits a chemotactic activity for monocytes and basophils but not neutrophils or eosinophils. May be involved in the recruitment of monocytes into the arterial wall during the disease process of atherosclerosis.
-
基因功能參考文獻:
- The expression of CX3CL1 and capital EM, Cyrilliccapital ES, Cyrilliccapital ER, Cyrillic-1 affect vital pulmonary capacity and forced expiratory volume in patients with asthma complicated by diabetes mellitus type 2. PMID: 29461240
- Aberrant histone modifications, including acetylation and tri-methylation, were found both in global histone and specific MCP-1 gene locos in monocytes from patients with coronary artery disease PMID: 29609686
- Alzheimer disease patients had higher plasma MCP-1 levels compared with mild cognitive impairment patients and controls, and severe AD patients had the highest levels. PMID: 29352259
- CCL2 played important roles in regulating platelet function and arterial thrombosis through the PKCalpha-P38MAPK-HSP27 pathway. PMID: 29864522
- Studied role of monocyte chemoattractant protein-1 (MCP-1) in migration of monocytes and lymphocytes during nickel induced contact hypersensitivity. PMID: 29132256
- High chemokine CCL2 expression is associated with colorectal cancer. PMID: 30419802
- NOX4 is induced in early alcoholic liver injury and regulates CCR2/CCL2 mRNA stability thereby promoting recruitment of inflammatory cells and production of proinflammatory cytokines. PMID: 28383062
- study confirmed the connection between high uMCP-1 levels and poor prognosis and also disease activity in antineutrophil cytoplasmic autoantibody-Associated Vasculitis (AAV); it also suggests an association of the A/A genotype at position -2518 in the MCP-1 gene and poor prognosis in AAV PMID: 29720895
- Given that IL-8, MIP-1beta, and MCP-1 are chemokines that play important roles in recruitment of immunocompetent cells for immune defense and tumor cell clearance, the observed lower levels of these markers with increasing PM2.5 exposure may provide insight into the mechanism by which DEE promotes lung cancer. PMID: 29023999
- In lupus nephritis, urinary MCP-1 and TWEAK possess higher correlation coefficients with renal damage and larger areas under ROC curves than other markers for rapid discrimination of severe disease. PMID: 29451067
- We propose that endogenous gC1qR/p33 physically interacts with MCP-1 causing stabilization of the MCP-1 protein and stimulation of its activity in human periodontal ligament cells, suggesting a novel gC1qR/p33-mediated pro-inflammatory mechanism of action. PMID: 29358188
- berberine inhibited the expression of MCP-1 and IL-8 induced by LPS. PMID: 28852897
- In Colombian systemic lupus erythematosus patients, urinary NGAL and MCP-1 in addition to anti-C1q antibodies were useful biomarkers for the identification of renal involvement and discrimination of active lupus nephritis. PMID: 29073812
- These results provide evidence that necrotic cells induce the expression of CCL2/MCP-1 and CCL20/MIP-3alpha in glioblastoma cells through activation of NF-kappaB and AP-1 and facilitate the infiltration of microglia into tumor tissues. PMID: 30048972
- Serum CCL2 and sICAM-1 concentrations were significantly decreased in CNS tumors in comparison with the comparative group. Among proteins tested in the serum, a higher area under the ROC curve (AUC) revealed CCL2 compared to sICAM-1 in differentiating subjects with CNS brain tumors from non-tumoral subjects. PMID: 29086194
- MCP-1 -2518 genotype may influence the outcome of nonsurgical periodontal treatment in aggressive periodontitis patients. PMID: 28427824
- Study describes how cysteine-rich 61 (CCN1) promotes monocyte migration by upregulating monocyte chemoattractant protein-1 (CCL2) expression in osteoblasts in rheumatoid arthritis (RA) disease. CCN1 could serve as a potential target for RA treatment. PMID: 28341837
- The MCP-1 concentration was positively correlated with blood pressure among smokers. PMID: 29098933
- CCL2-2518A/G (rs1024611) polymorphism is significantly associated with risk of gynecological cancer. PMID: 29458367
- High MCP1 expression is associated with pancreatic adenocarcinoma. PMID: 29205349
- Results provide evidence for MCP-1 involvement in the development of PVVs and indicate that inflammation could be implicated in the pathogenesis of this condition. PMID: 28623996
- Study found that the activation of CCR2 by its ligand CCL2 increased the expression of SMO and Gli-1, resulting in Hh pathway activation, epithelial-mesenchymal transition and hepatocellular carcinoma cell invasion. PMID: 29115520
- these findings collectively indicate that TGF-beta regulates CCL2 expression in a stage-dependent manner during breast cancer progression PMID: 29107385
- Individuals with rs1024611 AG and GG genotypes exhibited significantly higher susceptibility to Diabetic Foot Ulcers. PMID: 29995756
- REVIEW: regulation and importance of monocyte chemoattractant protein-1 PMID: 28914666
- this study shows that CCL2 promoter hypomethylation is associated with gout risk in Chinese Han male population PMID: 28690186
- Results showed that both heterozygous and homozygous genotypes are associated with age-related macular degeneration pathology. Allele frequency analysis showed that 'G' allele is frequent in AMD patients as compared to controls PMID: 29664944
- Oxidative stress markers in the pregestational period did not have a predictive value in the recurrent pregnancy loss and repeated implantation failure . CCL2 might be useful in risk prediction PMID: 28707148
- Distributions of MCP-1 -2518A/G and VEGF -634C/G polymorphisms are significantly different between type 2 diabetes mellitus and diabetic foot ulcer patients PMID: 29901584
- In multivariate analysis, the IL1B rs16944 TT and TNF rs1799964 TC genotypes were significantly associated with intrauterine cytomegalovirus infection. Twenty-two out of 72 congenitally infected newborns had confirmed sensorineural hearing loss. Carriers of CT or TT genotype of CCL2 rs13900 had increased risk of hearing loss at birth and at 6 months of age. PMID: 28501927
- Effective IL1beta and CCL2 antagonists are currently in clinical review to treat benign inflammatory disease, and their transition to the cancer clinic could have a rapid impact PMID: 28790030
- The genotype and allele frequencies between groups did not show significant differences. However, the GG genotype was the most frequent in children with insulin resistance. The GG genotype was associated with insulin resistance (OR = 2.2, P = 0.03) in a genetic model. Conclusion The -2518 A>G MCP-1 gene polymorphism may be related to the development of insulin resistance in Mexican children. PMID: 29694633
- the results of the present study confirmed CCL2 as a direct target of miR-206, and showed that the upregulation of CCL2 caused by the downregulation of miR-206 was responsible for the development of severe HEV71 encephalitis. PMID: 28765968
- data disclose the complexity of MCP-1 regulation upon CHIKV infection and point to a crucial role of IFNbeta in the chemokine secretion. PMID: 27558873
- The study suggests that MCP-1 (-2518A>G) AG genotype and G allele could be considered as risk factors for susceptibility to ovarian cancer. PMID: 28886321
- use of MCP-1/IL-10 ratio in combination with ultrasound findings appears to provide a promising modality for predicting preeclampsia PMID: 28038968
- It can be concluded that MCP-1 and CCR2 polymorphisms are not associated with AgP in Turkish population. PMID: 28458180
- Clathrithromycin suppressed TLR4-mediated MCP-1 production in human mesangial cells. PMID: 27614743
- CCL2 siRNA exhibited effective inhibition of cell proliferation and angiogenesis in the glioma cell line U251. PMID: 28714025
- CCL2 in addition to IFN-gamma can be used to differentiate among Mycobacterium tuberculosis infection possibilities. PMID: 28610785
- Results indicated that MCP-1 and CCR2 polymorphisms may influence the progression of IgAN, but not increase/decrease its susceptibility. PMID: 27788494
- Data suggest that, compared to control individuals, patients with T2DM-Y (young onset type 2 diabetes), NPDR (non-proliferative diabetic retinopathy) and PDR (proliferative diabetic retinopathy) exhibit significantly higher serum levels of MCP-1. This study was conducted in India. PMID: 28336215
- The meta-analysis demonstrated that urinary MCP-1 was significantly higher in patients with active LN than in those with inactive LN and control subjects, and the patients with inactive LN showed significantly higher urinary MCP-1 levels than the controls. PMID: 27278779
- investigated whether functional polymorphism at MCP-1 regulatory region associates with disease phenotype in Indian systemic lupus erythematosus patients (SLE) patients; findings suggest that -2518G allele of MCP-1 -2518 A/G polymorphism is associated with renal disorders and may influence MCP-1 gene expression among Indian SLE patients PMID: 28433894
- joint interaction analysis of ACE I/D and CCL2 C-2518T showed a significantly higher frequency of II genotype of ACE I/D in coexistence with TT genotype of CCL2 C-2518T in Henoch-Schonlein purpura (HSP) patients. PMID: 28691415
- EGF up-regulated CCL2 expression in HNSCC cells, which recruited monocytes and turned them into M2-like macrophages, thus forming a positive feedback paracrine loop. PMID: 27888616
- CCL2 gene silencing inhibits primary tumor growth and metastasis, associated with a reduction in cancer stem cell renewal and recruitment of M2 macrophages in triple negative breast cancer PMID: 27283985
- Mesenchymal stem cells from Ankylosing spondylitis patients secreted more monocyte chemoattractant protein 1 (MCP1) during abnormal osteogenic differentiation. PMID: 27921117
- CCL2 polymorphism is associated with susceptibility to latent tuberculous infection in well-defined North-East Thai populations. PMID: 27510253
- Meta-analysis suggests that the MCP-1-2518A/G polymorphism is associated with an increased risk of lupus nephritis. PMID: 29390552
顯示更多
收起更多
-
亞細胞定位:Secreted.
-
蛋白家族:Intercrine beta (chemokine CC) family
-
組織特異性:Expressed in the seminal plasma, endometrial fluid and follicular fluid (at protein level). Expressed in monocytes.
-
數據庫鏈接:
Most popular with customers
-
-
YWHAB Recombinant Monoclonal Antibody
Applications: ELISA, WB, IHC, IF, FC
Species Reactivity: Human, Mouse, Rat
-
Phospho-YAP1 (S127) Recombinant Monoclonal Antibody
Applications: ELISA, WB, IHC
Species Reactivity: Human
-
-
-
-
-